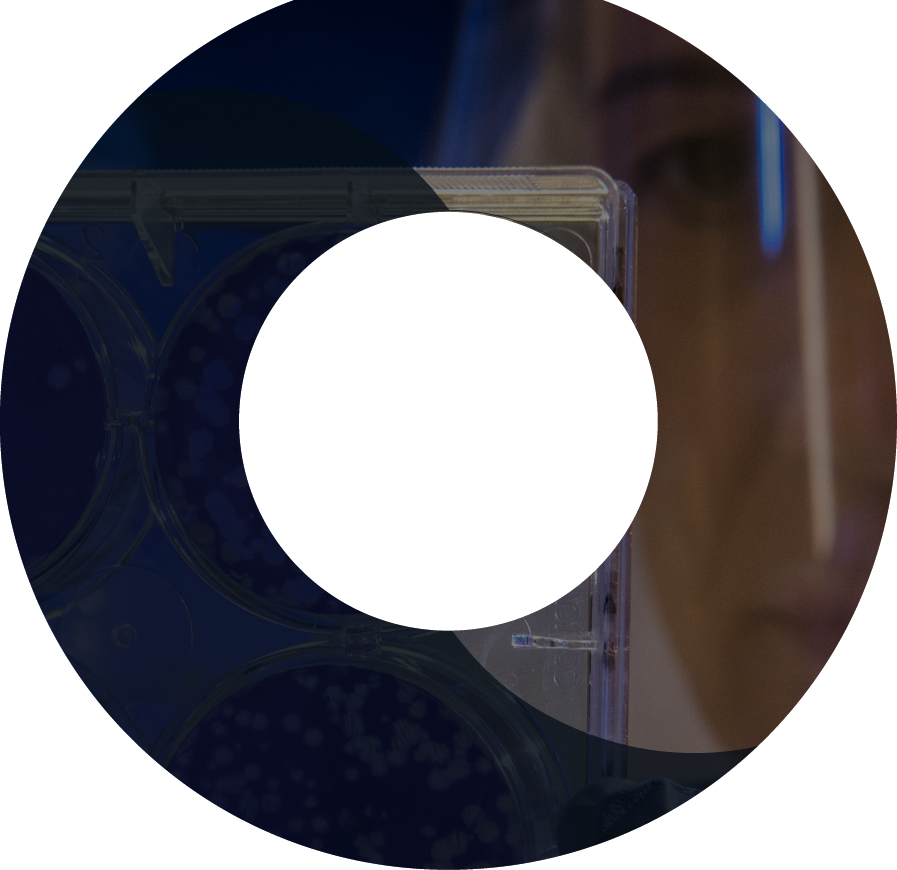
top_img2

IMPLEMENTATION OF INSTRUMENT RAW FILE MANAGEMENT SOLUTION
A Translational Medicine function operated in 5 different sites across the globe with varying levels of data management maturity. Working with the customer Zifo developed a file management solution built on enterprise IT data standards and using leading cloud storage technologies.
Key Statistics
-
Company of

Scientists
-
Across

Global Sites
-
Instrument data management deployed to

Users
-
Data Integrity & Access

Significantly Improved



There is nothing to worry about with this study when we’ve you! No one is raising any issues with data management 😊 – Medium Pharma